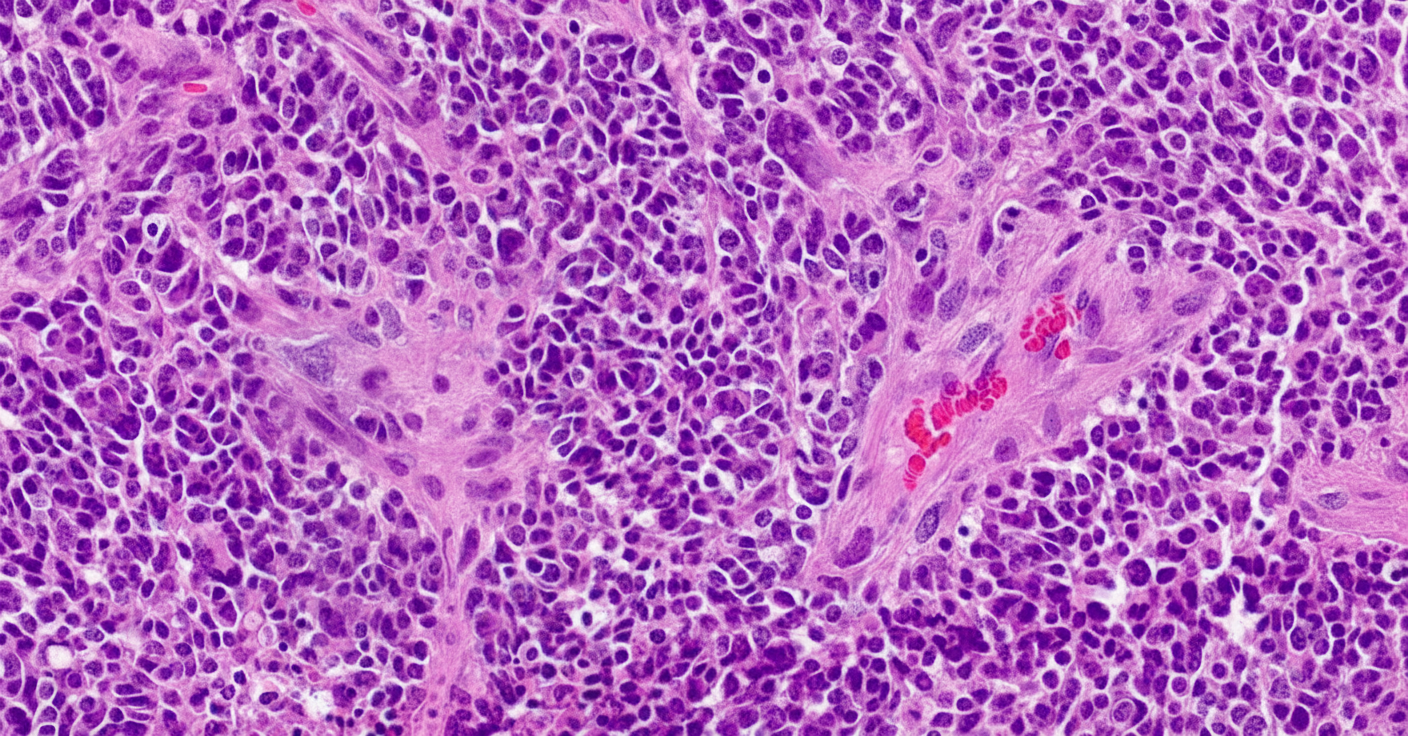
Image for question 1

Pediatric cancers strike differently than adult malignancies-they emerge from developing tissues, progress rapidly, and demand entirely distinct therapeutic approaches that balance cure with preserving growth potential. You'll master the critical triad of hematologic malignancies, CNS tumors, and solid tissue invaders that account for nearly all childhood cancers, learning to recognize their unique presentations, navigate risk-stratified treatment algorithms, and anticipate the long-term survivorship challenges that follow your young patients into adulthood. This knowledge transforms you from observer to advocate, equipped to deliver precision oncology while safeguarding the futures of your most vulnerable patients.
📌 Remember: CHILD mnemonic for pediatric cancer characteristics - Congenital predisposition, High cure rates, Immature tissue origin, Long-term survivorship issues, Developmental considerations in treatment
Pediatric cancers affect approximately 1 in 285 children before age 20, with distinct patterns:
| Cancer Type | Peak Age | 5-Year Survival | Incidence Rate | Key Features |
|---|---|---|---|---|
| ALL | 2-5 years | 91% | 26.3/100,000 | B-cell predominant |
| Brain Tumors | 5-9 years | 75% | 21.8/100,000 | Location-dependent |
| Neuroblastoma | <2 years | 81% | 6.2/100,000 | Adrenal primary |
| Wilms Tumor | 2-4 years | 93% | 5.1/100,000 | Renal origin |
| Lymphomas | 10-14 years | 88% | 13.7/100,000 | NHL > HL in children |
Pediatric malignancies demonstrate unique characteristics:
💡 Master This: Childhood cancers grow rapidly but respond dramatically to treatment because they retain embryonal characteristics - high mitotic rates, undifferentiated cell types, and preserved apoptotic pathways
Understanding these foundational principles establishes the framework for recognizing specific tumor presentations and optimizing age-appropriate treatment strategies that maximize cure while minimizing long-term sequelae.

📌 Remember: BLASTS mnemonic for leukemia recognition - Bone marrow >20% blasts, Lymphadenopathy, Anemia/bleeding, Splenomegaly, Thrombocytopenia, Systemic symptoms
ALL represents 25% of all pediatric cancers with remarkable cure rates:
| Risk Category | Criteria | Treatment Duration | Cure Rate | Key Features |
|---|---|---|---|---|
| Standard Risk | Age 1-9, WBC <50K | 2-2.5 years | 95% | Hyperdiploidy favorable |
| High Risk | Age >10, WBC >50K | 2.5-3 years | 85% | T-cell lineage |
| Very High Risk | Philadelphia+, MLL+ | 3+ years + BMT | 70% | Intensive protocols |
| Infant ALL | Age <1 year | Variable | 60% | MLL rearrangements |
AML accounts for 15-20% of pediatric leukemias with distinct characteristics:
💡 Master This: AML treatment success depends on cytogenetic risk stratification - core binding factor leukemias achieve 85% cure with chemotherapy alone, while 11q23/MLL rearrangements require bone marrow transplantation for optimal outcomes
Pediatric lymphomas demonstrate age-related patterns:
Non-Hodgkin Lymphoma (NHL):
Hodgkin Lymphoma:
⭐ Clinical Pearl: LDH >2x normal in pediatric lymphoma indicates high tumor burden requiring CNS prophylaxis and intensive protocols, while normal LDH suggests limited disease amenable to reduced-intensity treatment
These hematologic malignancies showcase pediatric oncology's greatest triumphs, with cure rates exceeding 85% through risk-adapted protocols that balance efficacy with long-term survivorship considerations.
📌 Remember: HICP mnemonic for increased intracranial pressure - Headache (morning, vomiting), Irritability, Cranial nerve palsies, Papilledema
Pediatric brain tumors demonstrate age-specific location preferences:
Infratentorial (Posterior Fossa) - 60%:
Supratentorial - 40%:
| Tumor Type | Peak Age | Location | 5-Year Survival | Treatment Approach |
|---|---|---|---|---|
| Medulloepithelioma | 5-9 years | Cerebellar vermis | 85% | Surgery + RT + Chemo |
| DIPG | 6-8 years | Brainstem | 10% | Radiation only |
| Pilocytic Astrocytoma | 8-12 years | Cerebellum/Optic | 95% | Surgery alone |
| Ependymoma | 2-6 years | Fourth ventricle | 75% | Surgery + RT |
| Craniopharyngioma | 8-12 years | Suprasellar | 90% | Surgery ± RT |
Medulloepithelioma dominates pediatric brain tumor statistics:
💡 Master This: Molecular subgrouping revolutionized medulloepithelioma treatment - WNT tumors require minimal therapy achieving 95% cure, while Group 3 demands intensive protocols including high-dose chemotherapy and craniospinal radiation
DIPG represents pediatric neuro-oncology's greatest challenge:
⚠️ Warning: Cranial nerve palsies with ataxia and long tract signs in school-age children indicate DIPG until proven otherwise - biopsy contraindicated outside research protocols
Modern pediatric neuro-oncology emphasizes:
Surgical Principles:
Radiation Therapy:
Chemotherapy Integration:
These CNS malignancies demand multidisciplinary expertise combining neurosurgical precision, radiation oncology, and molecular-targeted therapy to optimize functional outcomes while maximizing cure potential in developing brains.
📌 Remember: SOLID mnemonic for pediatric solid tumors - Sarcomas (bone/soft tissue), Osteosarcoma, Lymphomas, Intra-abdominal masses, Dermoid/teratomas
Wilms tumor exemplifies pediatric oncology success with 93% overall survival:
Staging System:
| Risk Group | Histology | Stage | Treatment | Survival |
|---|---|---|---|---|
| Very Low | Favorable | I, <2 years | Surgery + 18 weeks chemo | 99% |
| Standard | Favorable | I-II | Surgery + 18 weeks chemo | 95% |
| Intermediate | Favorable | III-IV | Surgery + RT + 24 weeks | 90% |
| High | Anaplastic | Any | Intensive multiagent | 70% |
| Very High | Anaplastic | IV | Intensive + RT + BMT | 50% |
Neuroblastoma demonstrates the widest spectrum of behaviors in pediatric oncology:

Risk Stratification:
💡 Master This: MYCN amplification overrides age and stage in neuroblastoma risk assessment - even localized tumors with MYCN amplification require intensive therapy due to high relapse potential
Osteosarcoma and Ewing sarcoma dominate pediatric bone malignancies:
Osteosarcoma Characteristics:
Ewing Sarcoma Features:
| Sarcoma Type | Peak Age | Location | 5-Year Survival | Key Features |
|---|---|---|---|---|
| Osteosarcoma | 13-16 years | Metaphyses | 70% | Alkaline phosphatase ↑ |
| Ewing Sarcoma | 10-20 years | Diaphyses | 65% | Fever, systemic symptoms |
| Chondrosarcoma | Rare <20 years | Pelvis/ribs | 80% | Cartilage matrix |
| Fibrosarcoma | <5 years | Extremities | 85% | Infantile type favorable |
Rhabdomyosarcoma leads pediatric soft tissue malignancies:
Treatment Principles:
These solid tumors demonstrate pediatric oncology's evolution toward risk-adapted therapy, function preservation, and long-term survivorship focus, achieving remarkable cure rates while minimizing treatment-related morbidity through precision surgical techniques and targeted therapeutic approaches.
📌 Remember: TREAT mnemonic for protocol selection - Tumor biology, Risk stratification, Early response, Age considerations, Toxicity profile
Contemporary pediatric oncology stratifies patients using multi-parameter algorithms:
Risk Stratification Parameters:
| Risk Category | Survival Target | Treatment Duration | Intensity Level | Monitoring Frequency |
|---|---|---|---|---|
| Very Low | >95% | 6-12 months | Minimal | Monthly |
| Low | 90-95% | 12-18 months | Reduced | Bi-weekly |
| Standard | 80-90% | 18-24 months | Standard | Weekly |
| High | 60-80% | 24-36 months | Intensive | Daily inpatient |
| Very High | 40-60% | 36+ months | Maximal + BMT | Continuous monitoring |
Pediatric chemotherapy requires weight-based calculations with organ function adjustments:
Dosing Calculations:
Common Pediatric Protocols:
ALL Treatment (Standard Risk):
💡 Master This: Therapeutic drug monitoring in pediatric oncology prevents under-dosing (treatment failure) and over-dosing (excessive toxicity) - methotrexate levels guide leucovorin rescue, while busulfan levels optimize conditioning regimens
Pediatric radiation requires specialized techniques to minimize growth and development impacts:
Age-Related Restrictions:
Technical Approaches:
| Age Group | CNS Dose Limit | Growth Impact | Fertility Risk | Secondary Cancer Risk |
|---|---|---|---|---|
| <3 years | Avoid if possible | Severe | Moderate | High |
| 3-7 years | 18-23.4 Gy | Moderate | Low-Moderate | Moderate |
| 7-12 years | 23.4-36 Gy | Mild | Low | Low-Moderate |
| >12 years | Standard doses | Minimal | Minimal | Low |
Pediatric oncologic surgery balances complete resection with functional preservation:
Timing Strategies:
Surgical Principles:
Infection Prevention:
Nutritional Support:
These treatment algorithms represent evidence-based medicine at its finest, incorporating decades of clinical trial data to optimize cure rates while preserving quality of life through precision therapeutic approaches tailored to individual patient characteristics and tumor biology.
📌 Remember: SURVIVOR mnemonic for late effects monitoring - Second cancers, Unfertility, Radiation effects, Vascular disease, Immune dysfunction, Vision/hearing loss, Organ dysfunction, Reproductive issues
Anthracycline cardiotoxicity represents the most life-threatening late effect:
Surveillance Protocols:
| Risk Factor | Relative Risk | Screening Interval | Intervention Threshold |
|---|---|---|---|
| Doxorubicin >300 mg/m² | 8.2x | Annual | LVEF <50% |
| Chest radiation >30 Gy | 6.1x | Annual | Wall motion abnormality |
| Combined therapy | 15.3x | Every 6 months | Symptoms + dysfunction |
| Age <5 at treatment | 4.7x | Biennial | Biomarker elevation |
Growth and development complications affect multiple endocrine axes:
Growth Hormone Deficiency:
Thyroid Dysfunction:
💡 Master This: Precocious puberty occurs in 20% of cranial radiation survivors due to hypothalamic dysfunction, requiring GnRH agonist therapy to preserve final adult height and psychological well-being
CNS treatment creates lifelong learning challenges:
Cognitive Late Effects:
Academic Interventions:
Psychosocial Considerations:
Treatment-related cancers represent leading cause of late mortality:
Radiation-Induced Cancers:
Chemotherapy-Related Malignancies:
| Treatment Exposure | Cancer Type | Latency | Cumulative Risk | Screening Recommendation |
|---|---|---|---|---|
| Chest radiation | Breast cancer | 8-10 years | 13-20% | Annual MRI age 25+ |
| Alkylating agents | Bladder cancer | 10-15 years | 2-5% | Annual urinalysis |
| Anthracyclines | Cardiomyopathy | 5-20 years | 5-10% | Echo every 2 years |
| Cranial radiation | Brain tumors | 10-20 years | 1-3% | MRI every 5 years |
Gonadal dysfunction affects family planning and quality of life:
Male Fertility:
Female Fertility:
This multi-system integration approach transforms childhood cancer survivors from patients to partners in lifelong health management, emphasizing prevention, early detection, and quality of life optimization through evidence-based survivorship care.
📌 Remember: URGENT mnemonic for oncologic emergencies - Upper airway obstruction, Raised ICP, GI bleeding, Electrolyte crisis, Neutropenic fever, Tumor lysis syndrome
The 3-Minute Oncology Assessment:
Primary Survey (30 seconds):
Secondary Survey (2.5 minutes):
| Clinical Scenario | Key Features | Time to Action | Critical Intervention |
|---|---|---|---|
| Neutropenic Fever | ANC <500, Temp >38.3°C | <60 minutes | Broad-spectrum antibiotics |
| Tumor Lysis | K+ >6, Phos >6.5, Ca <7 | <30 minutes | Dialysis consideration |
| SVCS | Facial swelling, stridor | <15 minutes | Airway management |
| Raised ICP | Headache, vomiting, bradycardia | <30 minutes | Osmotic therapy |
| Spinal Compression | Back pain, weakness | <4 hours | MRI + steroids |
Diagnostic Laboratory Patterns:
Leukemia Indicators:
Solid Tumor Markers:
💡 Master This: Tumor lysis syndrome prevention requires aggressive hydration (3 L/m²/day), allopurinol (300 mg/m²), and rasburicase for high-risk patients with LDH >2x normal or large tumor burden
Early Response Indicators:
Day 8 Peripheral Blast Count (ALL):
Minimal Residual Disease (MRD):
Imaging Response (Solid Tumors):
Neutropenic Fever Protocol:
Tumor Lysis Syndrome Management:
Superior Vena Cava Syndrome:
Risk Stratification Synthesis:
| Factor | Low Risk | Intermediate Risk | High Risk | Very High Risk |
|---|---|---|---|---|
| Age | 1-9 years | <1 or >10 years | Infant | Adolescent |
| WBC | <50,000 | 50-100,000 | >100,000 | >200,000 |
| Cytogenetics | Hyperdiploidy | Normal | Complex | Philadelphia+ |
| Response | Day 8 <1,000 | Day 8 1-5,000 | Day 8 >5,000 | MRD+ End-Induction |
| Treatment | Standard | Intensified | High-intensity | Experimental |
This clinical mastery arsenal transforms pediatric oncology complexity into systematic excellence, enabling rapid recognition, appropriate triage, and optimal outcomes through evidence-based decision making and coordinated multidisciplinary care.
Sign up for free to access the full lesson, plus unlimited questions, flashcards, AI-powered notes, and more.
CONTINUE READING — FREEor get the app
Have doubts about this lesson?
Ask Rezzy, your AI Study Mate, to explain anything you didn't understand
Test your understanding with these related questions
A previously healthy 4-year-old girl is brought to the physician for evaluation of a 3-week history of recurrent vomiting and difficulty walking. Examination shows a broad-based gait and bilateral optic disc swelling. An MRI shows an intracranial tumor. A ventriculoperitoneal shunt is placed, and surgical excision of the tumor is performed. A photomicrograph of a section of the tumor is shown. Which of the following is the most likely diagnosis?